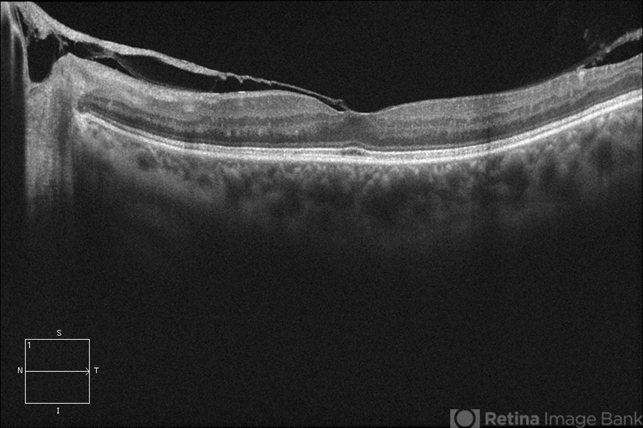

-
 By Eduardo Torres-Porras, MD
By Eduardo Torres-Porras, MD
PROVISSIA
Co-author(s): Humberto Ruiz Garcia - Uploaded on Mar 14, 2013.
- Last modified by Caroline Bozell on Mar 15, 2013.
- Reviewed by Caroline Bozell
- Rating
- Appears in
- Miscellaneous
- Condition/keywords
- vitreomacular traction (VMT), 20/25, optical coherence tomography (OCT)
- Photographer
- Eduardo Torres Porras, Laser y Ultrasonido Ocular de Puebla
- Imaging device
-
Optical coherence tomography system
Cirrus - Description
- OCT of an 56-year-old woman with diabetic retinopathy, VA 20/25.

Initializing download.
Initializing download.










